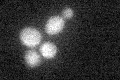
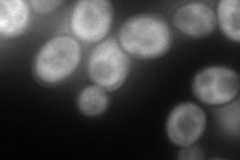

View description
N-terminally acetylated protein component of the large (60S) ribosomal subunit, has similarity to Rpl6Bp and to rat L6 ribosomal protein; binds to 5.8S rRNA
Localization:
Intensity:
Fold change:
Significance:
-
C’ GFP library in SD
below threshold17.15 -
N' NOP1pr-GFP in SD

cytosol193.863 -
N' TEF2pr-mCherry in SD
cytosol296.78 -
N' NATIVEpr-GFP in SD

below threshold18.5603 -
N' TEF2pr-VC and Cyto-VN in SD

#N/A0 -
C’ GFP library in SD+DTT

cytosol17.721.03No -
C’ GFP library in SD+H2O2

cytosol17.10.99No -
C’ GFP library in Starvation Media

cytosol16.870.98No -
C’ GFP library on the background of Pup2-DaMP

below threshold -
C’ GFP library on the background of CCT mutant

below threshold17.3521.01116No
